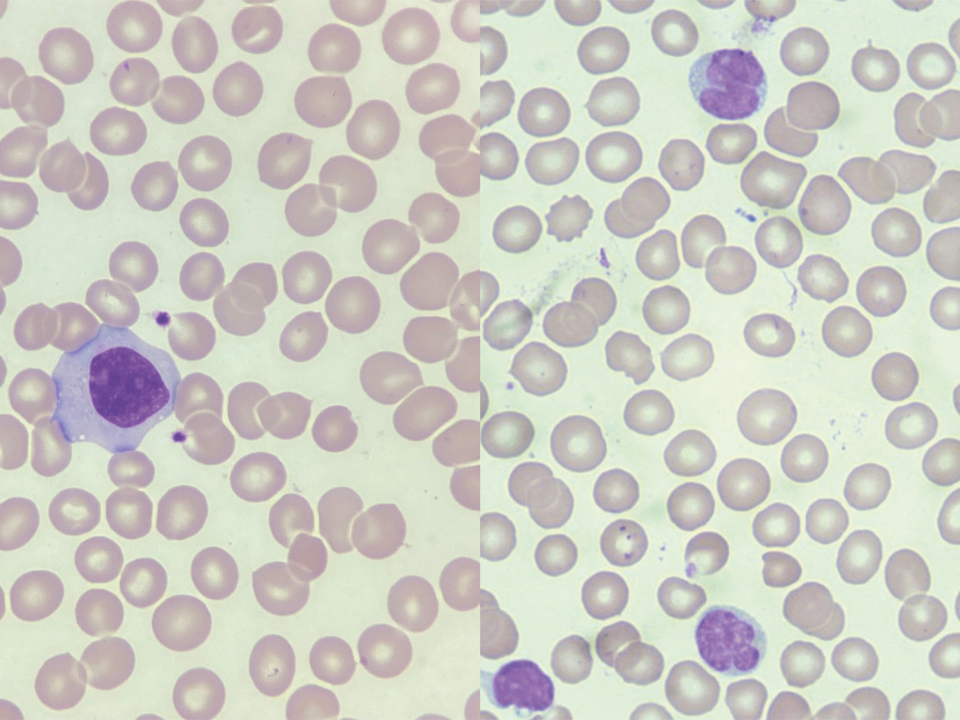

A mononucleose infecciosa, conhecida como “doença do beijo”, é causada pelo vírus Epstein-Barr (EBV) e acomete frequentemente jovens e adultos. Seus principais sintomas incluem febre, fadiga, dor de garganta e aumento dos linfonodos, além de linfócitos reativos detectados no hemograma. Apesar dos desconfortos, o prognóstico costuma ser benigno, com recuperação após algumas semanas.
Por outro lado, o linfoma de células do manto é uma neoplasia hematológica agressiva que afeta predominantemente homens acima dos 60 anos. Ele resulta de uma translocação genética (t(11;14)) que aumenta a expressão da ciclina D1, levando à proliferação descontrolada das células B. Os pacientes apresentam linfonodos aumentados, sintomas como febre, suores noturnos e perda de peso inexplicada. Seu diagnóstico depende de técnicas avançadas, como imunohistoquímica e estudos genéticos, e o tratamento exige quimioterapia e imunoterapia, com prognóstico mais reservado.
Ambas as condições podem causar linfadenopatia e fadiga, mas requerem abordagens diagnósticas e terapêuticas totalmente distintas. A diferenciação entre elas baseiam-se em diversos fatores.
E você, consegue distinguir células da mononucleose e do manto?
Torne-se um Especialista na Área!
Quer dominar os fundamentos da diferenciação celular e diagnósticos hematológicos? Inscreva-se na Pós-Graduação em Hematologia Laboratorial e Clínica do Instituto Nacional de Medicina Laboratorial. Aprenda com profissionais renomados e torne-se referência em análises hematológicas. Para mais informações, visite nosso site ou entre em contato conosco!
Contato:
Site: inml.com.br
E-mail: atendimento@inml.com.br
Tel: +55 73 99151-9694
Instagram: @inml.brasil